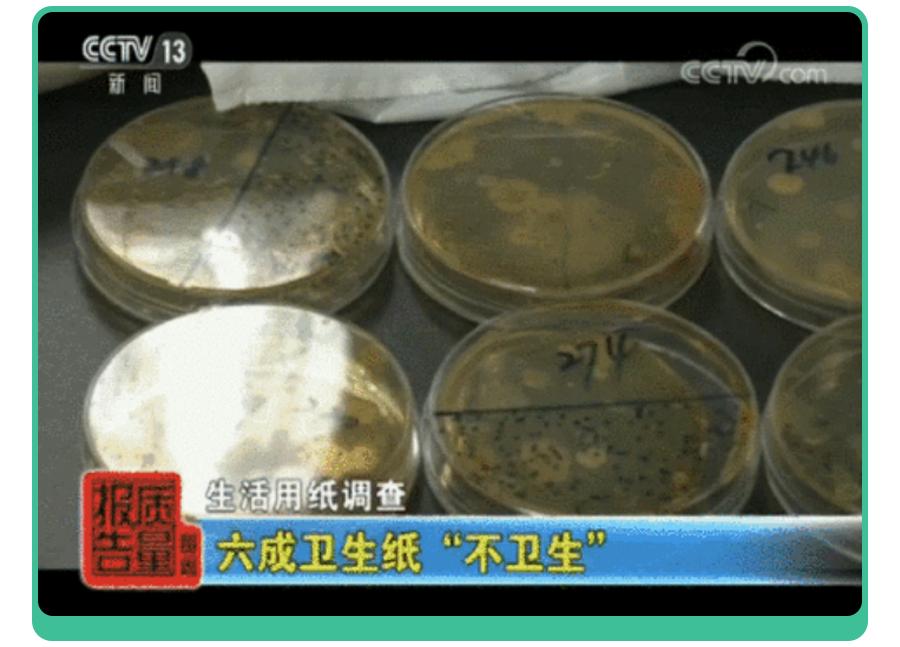
女童患妇科病,如何判断女童是否感染妇科疾病

#从今天起记录我的2023#
前段时间,一条关于卫生纸有毒的新闻登上热搜,瞬间引起全网热议!

以前人们都说病从口入,现在好像不一腚了!
关于卫生纸的安全问题,一直都存在,这次被曝出的 永久性化学品会对人体造成怎样的伤害?生活中还有哪些产品中含有它?
日常用的卫生纸、抽纸、湿厕纸该怎么挑?
孩子用的湿巾、棉柔巾、云柔巾能放心用吗?
今天我们就来聊聊“用纸安全”。

全氟烷基和多氟烷基物质(PFAS)被一些科学家称为最毒、最阴险的化学物。这种物质不仅只藏在卫生纸中。
像 厨房的不粘锅、食品接触用纸和纸板、纺织品、油漆、蜡、抛光剂、遮瑕膏、粉底、眉笔和口红等都有应用PFAS。

图片来源:科学家庭育儿原创
由于全氟烷基和多氟烷基物质(PFAS),无法自然分解。
擦完屁股的纸被冲下马桶并被送往污水处理厂时,这些化学物质混在处理厂的污水污泥中,最终作为肥料扩散到农田里,或者泄漏到水道中,将会造成 严重的水污染。
当未分解的PFAS进入人体后先与血清蛋白结合,然后沉积到肝脏、肾脏及*丸睾**等脏器。
从而会 诱发甲状腺疾病、肾癌、*丸睾**癌、妊娠高血压综合征、胎儿并发症、溃疡性结肠炎 和其他严重的健康问题。

图片来源:科学家庭育儿原创
虽然目前各国已经从严管控了,但美国疾病控制和预防中心2007年的一项研究估计,98%的美国人口的血液中可以检测到PFAS化学物质。

图片来源:科学家庭育儿原创
所有这些日用品中,纸巾使用频率是最高的,为了防患于未然,大家在购买纸巾时要留意。
下面我们再来聊聊 如何选卫生纸、抽纸、婴幼儿棉柔巾、湿纸巾以及最近超火的湿厕纸。

目前国内的卫生纸并未有关于含有PFAS的报道,但爱看新闻的朋友,应该注意到过央视曾专门曝光过一些黑作坊加工劣质纸巾的过程。
其中抽检的样品中,大家常用的品牌也被曝过不合格。

有的造纸厂不仅生产环境恶劣,还粗制滥造,生产的纸巾里检测出了甲醛、漂白剂、荧光剂和滑石粉等有害物质。
甚至有的细菌总数也是严重超标的。
还有的是因为 “缺斤少两” ,有的一包少四分之一,有的一包少32抽。

喜欢网购纸巾的朋友注意啦,此类 不合格样品均是从电商平台采购的。
不合格的纸巾对大人和小孩的危害可不少。类如
1.皮肤过敏、起皮疹
像荧光剂、漂白剂超标的纸,会对皮肤产生刺激,会引起 过敏、皮疹 等问题。
如果不慎进入口中还会导致肠胃不适,有的还会导致视力下降,重则会诱发癌症等。

图片来源:科学家庭育儿原创
2.诱发妇科病
如果是细菌超标的纸,使用后可能会导致细菌感染,引发疾病。有的女孩甚至因为 擦屁屁,擦出了妇科病。
此前因细菌菌落总数超标被曝光的卫生纸品牌有: “永星”“洁通”“雪莲公主”“帕奇多”“妙悦”“肤之友”“徐阳”“洁伴” 等。
大家看看家里有没有买过?

3.影响宝宝智力发育
劣质纸巾中的滑石粉含有铅、镉等重金属, 孕妈和宝宝长期使用会影响孩子的神经系统、血液系统甚至是导致宝宝智力障碍。
所以,家长们在挑选纸巾时要格外注意。
如果你的纸巾是9.9十包,5块8四包,甚至是直播间1分钱抢的,很有可能就是不合格的。
下面科大大就手把手教大家选卫生纸、抽纸、棉柔巾、湿厕纸。
一、卫生纸和抽纸
①看纸巾的外包装
外包装会表明纸巾执行标准、纸张所用原料、质量等级。
·看纸巾执行标准: 卫生纸执行标准GB/20810,细菌菌落总数<600cfu/g;提醒:别用卫生纸擦嘴!

纸巾纸执行标准GB/T208208,细菌菌落总数<200cfu/g。

·看横向抗张指数: 卫生纸遇水易碎,不会堵马桶;而纸巾纸的横向抗张指数高,湿水后不易断。
·看原料: 竹浆、木浆,可能用的是被回收或再生原料(回用浆);原生竹浆、原生木浆,用的就是全新原料,不管是卫生纸还是抽纸最好选原生竹浆或原生木浆的。

直播间抢来的便宜纸巾
·看质量等级: 卫生纸分为合格品、一等品、优等品;纸巾纸分为合格品、优等品,等级越高吸水性和柔韧性越好。
有的纸巾还分为超柔型和普通型,敏感肌有鼻炎的可选择超柔型的。
·看颜色: 通常纸巾呈现米白色或原木白为正常色,如果纸张过于发白,小心添加了荧光剂等有害物质。

想看有没有荧光剂的朋友,可以用验钞笔来检验,含有荧光剂、漂白剂的纸巾会呈现蓝紫光。
②摸纸巾的手感
·柔软度: 优质纸巾摸起来是细腻柔软的,劣质的则偏硬松散,去小餐馆或美食城吃饭就能见到很多劣质纸巾。一擦会掉纸屑甚至会粘得满嘴是纸沫。
·韧度: 优质纸巾弹性和抗拉强度较好,不会一撕就破或者掉纸屑灰尘。劣质纸巾很容易撕开,而且容易断,会掉粉末渣渣。
③闻气味
优质的纸巾几乎是没有味道的,会有一些 木质香味 ,但绝不会有刺鼻的气味, 如果纸巾有刺鼻的化学味道一定别买。
④试用
优劣纸巾擦在手上、脸上的质感是不一样的。如果感觉柔软舒服,没有磨蹭皮肤的生硬感就是好纸巾。
也可以将不同的纸巾放入水中,观察纸巾状态。

劣质的纸巾被水泡后容易变成渣,拎不起来。
优质的吸水后依然成型。

二、湿厕纸和湿巾纸
·选正规大品牌大厂产品 ,符合湿巾国标GB/T27728及一次性使用卫生用品卫生执行标准GB 15979。
·看成分:
湿厕纸,看液体成分,纯水为宜。无有害添加物。

湿纸巾,不选含有丙二醇、苯甲酸钠、十六烷基氯化吡啶、氯己定二葡糖酸盐等添加剂的。

·看是否会连抽:
湿厕纸和湿纸一旦抽出来就不好放回去,容易形成二次污染。
挑选湿厕纸时还要注意看外包装是否有 “可丢入马桶”、“可冲散”字样 ,以及 是否通过国家阴道黏膜测试的标识。

擦完如果有水分残留的,记得再用卫生纸轻擦一下,不然过度潮湿也会滋生细菌,或出现妇科炎症、肛周湿疹等。
如果家里有条件的,可以 直接使用智能冲洗马桶 ,省事直接还干净卫生。
三、婴儿棉柔巾和云柔巾
目前国家还没有针对棉柔巾的国标, 多数品牌生产制作时执行的是 GB 15979《一次性使用卫生用品卫生标准》。
但部分品牌会有自己的企业生产执行标准和国家认证的卫生许可证,多重保证棉柔巾成品的安全性。

图片来源:科学家庭育儿原创